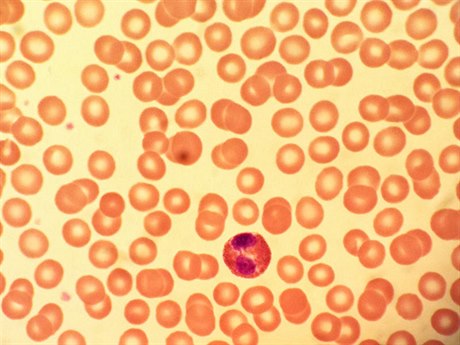
Mikroskopický snímek lidské krve. Pevládají ervené krvinky, které jsou pi...

Tato zpráva by byla relevantní, kdyby se neopírala o nějaké torzo zprávy o výzkumu a kdyby někdo před jejím publikováním alespoň trochu kriticky přemýšlel, protože ze „zprávy“ vůbec nevíme, zda to, co čínští vědci objevili, je kauzalita, nebo čirá koincidence.
Velký manuál ke koronaviru od expertů z Bulovky: co víme, proč zůstat doma a jak se ochránit |
Za prvé, v různých populacích se četnost krevních skupin liší, planetárně je nejhojnější skupina O, u nás skupina A. Číňané zkoumali vzorek 2000 pacientů, o němž nemáme žádné informace, pokud jde o poměrné zastoupení jednotlivých krevních skupin v něm.
Za druhé „zpráva“ nám sugeruje, že nejbezpečnější má být skupina O a nejrizikovější A, přičemž připouští fakt, že o ostatních krevních skupinách text nehovoří. To je ale přece krajně podezřelé. Lze předpokládat, že si v nemocnici výzkumníci nevybírali do vzorku pacienty přesně podle proporcionálního zastoupení krevních skupin v populaci, stejně nezkoumali ani jiné diagnózy těchto nemocných.
Nevíme tedy, kolik mezi nakaženými bylo starých či jinými nemocemi oslabených jedinců. Těžko to lékařům vyčítat, vzorek jim patrně „vybrala“ epidemie a na to, jak je z hlediska statistiky relevantní vůči populaci, se nedívala. Tvrzení vědců tedy platí možná pouze na zkoumaný vzorek.
Zkrátka podobně nastavené „šetření“ může přinést poznatek, že dnes na Hlavním nádraží v Praze svůj spoj stihlo 98 procent žen s pokrývkou hlavy, ale jen 84 procent mužů bez pokrývky hlavy. Do titulku pak můžeme dát tvrzení: Když budete mít čepici, neujede vám vlak.
Nestrašme se zbytečně a čtěme opatrně, co nám média hladová po všech podrobnostech okolo koronaviru servírují, a držme se doporučení vlády a především tuzemských lékařů.